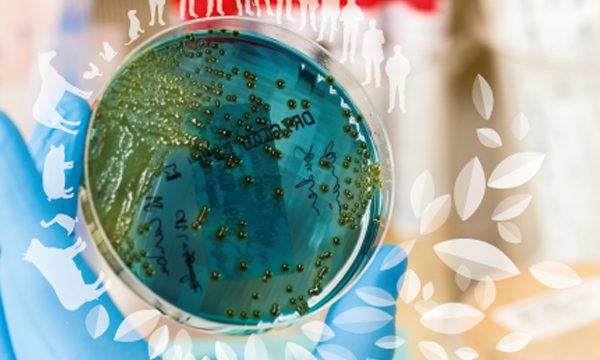
Edito antibiorésistance

« L’Europe unie dans la lutte contre l’antibiorésistance » : un éditorial avec la participation de RESINFIT
L’interface nationale Antibiorésistance a pour rôle de rendre visible la recherche française autour de l’antibiorésistance, de permettre l’accès à l’ensemble des recherches et informations portées par les différents acteurs (organismes, instituts de recherche, actions européennes et internationales, etc.), de faciliter et d’assurer la continuité et le partage d’informations émises par les ministères français et Santé publique France, en charge de la surveillance.
Régulièrement, cette interface met à disposition des éditoriaux, centrés sur une thématique particulière ou un projet par exemple, accessible par tous les internautes. L’édito de mars 2025 a été réalisé par Evelyne Jouvin-Marche (Coordinatrice scientifique du PPR Antibiorésistance) mais également par deux membres de notre UMR 1092 RESINFIT : Marie-Cécile Ploy, Directrice du laboratoire, mais aussi Yohann Lacotte, chef de projet PROMISE et EU-JAMRAI 2.
Dans cet éditorial, il est en effet question de l’action conjointe européenne sur la résistance aux antimicrobiens et les infections associées aux soins (EU-JAMRAI), coordonnée par la France au nom de l’Inserm – notamment via l’UMR 1092 RESINFIT. Plus généralement, cette publication propose un focus sur le concept One Health, pour faire face à la dimension globale de la résistance aux antimicrobiens.
- Accéder à l’éditorial « L’Europe unie dans la lutte contre l’antibiorésistance » sur l’interface nationale Antibiorésistance


